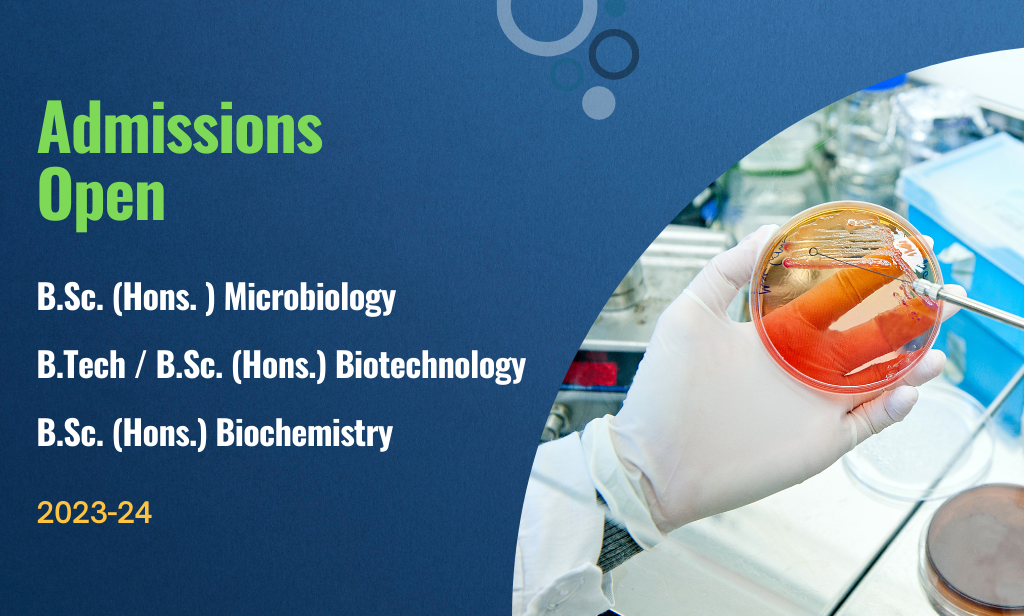
image

WELCOME TO Mata Harki Devi College for Women
TOP PRIVATE COLLEGE IN INDIA
A true epicentre of Learning
Mata Harki Devi College for Women is affiliated to Ch. Devi Lal University, Sirsa. It was founded by Mata Harki Devi Educational Society, a registered Trust comprising scholars, educationists and professionals committed to empowering young girls from rural areas through education. The lush green campus spreading in 18 acres of land is situated at Odhan in Sirsa district.

Smart Class Rooms, EQUIPEE Labs, Auditorium, E-library, National and International level Sports Grounds etc.

Highly qualified versatile staff. Students from every corner of India.

The only institute that trains students for national and international Games.

To provide professional and skill based courses for Government and Market needs.

Dear students, I want to start by saying thank you for taking into consideration Mata Harki Devi Group of Institutions. You will be able to choose your course at our college while you browse this website. I am confident that you will enjoy your time as a student at MHD and that it will provide you with the necessary stepping stones to achieve your goals of finding Read More
- Dr. Kuldeep Kaur
- Director

Welcome to Mata Harki Devi College For Women. The college is affiliated to Chaudhary Devi Lal University, Sirsa. It was founded by Mata Harki Devi Educational Society, a registered trust comprising of scholars, educationists and professionals committed to empower women of rural areas through education.
Read More
- Dr.Abhilasha Sharma
- Principal
A GALAXY OF INTERDISCIPLINARY LEARNING
Mata Harki Devi College for Women is the only exclusive college for girls. The majority is of the girls from this area are unable to pursue higher education due to many socio-economic factors
Mata Harki Devi College
Mata Harki Devi College has been established to fill this void. The location of the college facilitates girls from the surrounding areas to pursue higher education as day